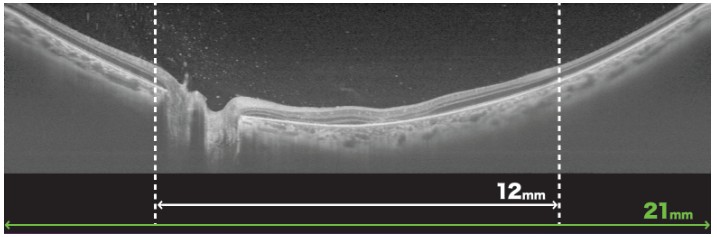

検査機器のご紹介
・電子カルテ IMAGEnet eカルテV5(Topcon)
・三次元画像解析装置 Triton Plus Pro(Topcon)
・広角眼底カメラ Optos Carifornia RGB(Nikon)
・自動視野計 アイモvifa Pro(クリュートメディカルシステムズ)
電子カルテ IMAGEnet eカルテV5(Topcon)
Topcon社のIMAGEnet eカルテV5は、眼科専用メーカーが開発した眼科専用の電子カルテです。臨床から研究まで、様々な環境で対応が可能なシステムで、全国の大学病院や総合病院等でも広く導入されております。当院で導入した電子カルテはオンプレミス型といって、クラウド型のようなインターネット環境で使用するものではなく、院内サーバーを設置してクリニック内のみでの限られた環境におけるネットワークで構築されており、セキュリティ面も含めて安心できるシステムです。また日本医師会の標準レセプトソフトであるORCAとも連携し、受付・診療から会計業務に至るまで、スムーズな対応が可能となっております。

画像鮮明化ソフト Mier(Logic &Design)
画像鮮明化ソフトのMier(ミエル)は、眼底写真など眼科の検査で得られた画像を独自に処理することで、画質を向上させ、より病変などを確認しやすくするソフトウェアです。特に広角眼底カメラとの相性がとてもいいことが知られており、従来の検査では見逃しがちであった小さな病変などの早期診断につながることが大いに期待されます。日本が世界に誇る技術の一つです。 当院でも同ソフトを導入し、病変の見逃しなどを極めて最小限にすることで、皆さんの眼の健康をより高いレベルで守っていけるように努めております。

近視進行評価機器 MYAH(Topcon)
MYAHは眼軸長測定検査や角膜形状解析、ドライアイ診断など多くの機能を併せ持つ機器です。特に子供の近視治療において、短時間で眼軸長測定や角膜形状解析が可能であり、眼軸長の進展をモニタリングすることで近視進行の程度を時系列にしてグラフ化します。さらにアジア人のデータを基に作成された成長曲線との比較を行うことで、進行速度についてもより的確に評価し、皆さんに現状を可視化してお伝えすることが可能となりました。 当院ではこのMYAHを北海道初導入しました。子供たちの近視について評価するとともに、治療も含めて眼のことについて皆さんにご興味を持ってもらえるよう、また治療の効果などについても的確に状況をお伝えしながら相談できるよう、体制を整えております。


三次元画像解析装置 Triton Plus Pro(Topcon)
三次元画像解析装置(OCT)は現代の眼科に必要不可欠な機器の一つで、主に網膜の層構造を詳細に可視化することで、多くの網膜病変の発見や評価、また治療効果の判定などが的確に行えるようになりました。また視神経乳頭周囲の神経線維の厚さを解析することで緑内障の評価が可能となったり、Angiographyといって網膜血管や脈絡膜血管の血流を造影剤を用いることなく評価することができ、低侵襲で眼底の状態を把握することができるようになりました。 Triton Plus ProはTopcon社が提供する最新鋭のOCTで、眼科臨床で必要とされるすべての機能を高いレベルで可視化することができ、従来機器では評価が難しかった硝子体や網膜、脈絡膜までも鮮明に描写されるようになりました。

広角眼底カメラ Optos Carifornia RGB(Nikon)
Optosは眼底・網膜の写真を撮る機器です。これまでの機器では散瞳薬で瞳孔を開いてから、眼底のほんの一部だけを写真に収めることしかできず、眼底全体の評価はできませんでした。このOptos Carifornia RGBはたった1回の撮像で眼底のほぼ全体の評価が可能で、散瞳せずともある程度の画像を得ることが可能になりました(もちろん散瞳するほうがよりきれいで正確な画像が得られます)。急な飛蚊症などで車の運転で来院されても、散瞳せずにある程度の眼底を評価できるので、帰り道も安心です。まぶしがって眼底検査が難しいお子さんにも有用です。


自動視野計 アイモvifa Pro(クリュートメディカルシステムズ)

眼軸長測定&前眼部解析装置 Eyestar 900(Haag-Streit)
Eyestar 900は最新のswept-source OCTを搭載し、独自のスキャン技術であるマンダラスキャンによる高密度なデータを基に角膜形状解析や水晶体を含む前眼部構造の評価を行うことで、白内障術前の手術計画をより高精度に行うことを可能にした次世代機器です。両眼を同時に測定できるため、検査時間の短縮も一つのメリットになります。現在の白内障手術は、従来のような濁りを取り除いてレンズを入れて終わりではなく、術後の見え方をいかに希望通りに提供できるかという側面が強くフォーカスされるようになり、より良い結果を得るためには術前の眼のバイオメトリー検査が非常に重要な意味を持ちます。当院ではこのEyestar 900を用いて白内障の術前検査を行い、より皆さんの希望に近い形での手術結果を提供できるよう努めます。


前房蛋白細胞測定装置 レーザーフレアメーター(興和)
レーザーフレアメーターは、簡単にお伝えすると眼の中の炎症の程度を数値化できるようにした装置です。白内障などの眼の手術前後の眼炎症評価のほか、ぶどう膜炎など炎症性疾患において活躍します。眼の中の炎症がどれほど強いのか、活動性の強いのかなど、従来は医師が自分で顕微鏡で診て判断するしかなく、医師の感覚や経験を頼りに治療を決めておりました。このフレアメーターを用いることで炎症が定量化され、微細な炎症の見逃しを防ぐほか、術後の炎症評価ならびに炎症に対する点眼治療の効果判定なども定量化して行うことが可能となりました。

自動視野計 ハンフリー視野計(Carl Zeiss)
緑内障の進行などの評価には視野検査が必須です。ハンフリー視野計はほとんどの眼科に導入されている機器の一つで、安定した信頼のおける視野結果を提供が可能です。機器に顔をしっかり乗せ、中心の視標をずっと見てもらいながら、中心付近や少し周辺部視野まで、点灯している光が見えるかどうかをチェックします。検査を受ける側にもコツや慣れが必要で、信憑性の高い結果を得るには何度も検査をしなければならないこともあります。緑内障にも程度がありますが、初期・中期・後期視野までの”進行判定”に向いています。この緑内障の検査においてとても大事なことの1つであり、1回だけの検査ではなく、定期的に検査を繰り返していくことで、進行が早いのか遅いのかを判断できますので、どうか治療の自己中断は避けていただくよう心がけてください。

動的視野計 ゴールドマン視野計(タカギセイコー)
血流画像化装置 レーザースペックルフローグラフィー(ソフトケア)
レーザースペックルフローグラフィーは、眼底の血流を非接触で表示し、血流分布を可視化・数値化することが可能な装置です。特に視神経乳頭周囲の血流評価は、緑内障や様々な全身疾患を反映していることが知られております。血流というのは見た目だけでは分かりません。虚血性視神経症など、見た目では分かりづらい視力障害においても簡単に評価が可能であり、加えて血流を数値化できるという大きなメリットは、臨床はもとより、臨床研究においてもこの機器が広く用いられてきました。血流障害を主とする糖尿病網膜症や網膜静脈閉塞症などの眼底疾患においても、病勢の評価目的に検査を行うことがあります。
